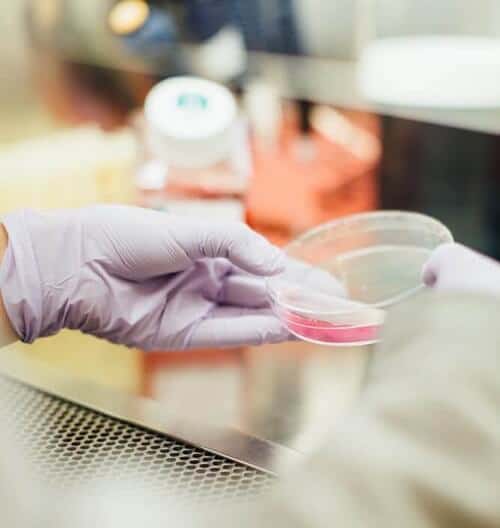

Nayon Exports has been on the forefront of garment manufacturing since inception in 1973. With three fully compliant and SEDEX certfied factories, we are able to export an upwards 4 Million garments per year. On an average, we are able to manufacture 350,000 garments per month. Our lean manufacturing processes in all our factories allow us to produce womens apparel in both knits & woven categories. Our strong supply chain for sustainable & imported fabrics in these categories allow us to expose our customers to a variety of collections.
Capabilities
Design
Our in-house fashion and graphic designers plan and execute the first phase of our apparel supply chain; design. With the use of sustainable & fresh fabrics, highly automated softwares for pattern making, imaging & designs our teams put together trend appropriate product lines. This helps kick-start the first step the journey of every carefully curated product.
Testing
A garment’s internal test is the first step we take to ensure a products shelf life is maintained and a superior product is delivered to our customers. Before bulk fabrics are ordered, we perform a series of internal tests at our in-house testing facility and our fabrics and garments are also shared with recognized labs for a more in-depth analysis & quality check.
Furthermore, every fabric we receive at any of our compliant factories for production are scrutinised and checked for various parameters & only after this do we begin the first step of the production cycle.
Cutting & Spreading
One of the most important aspects of the garment industry is cutting & spreading of fabrics. At this stage a more in depth check of fabrics is carried out as each yard is calculated and layed on large tables for cutting. With the use of highly automated CAD softwares, we are able to achieve maximum cutting efficiency and minimal wastage of our fabrics. All our employees in this department are take proper safety measures while cutting fabrics.
Printing
In our attempt to increase our vertical scalability, we have heavily invested in garment printing techniques(screen prints, transfer prints, etc..) that make our sampling & production processes as seamless as possible. Having this process in-house helps us keep up with a constantly evolving requirement in print techniques, production lead times and customization.
Stitching
As one of the most important part of the process, our stitching lines are built with highly skilled labor and in-line quality assurance systems that ensure minimum wastage and maximum efficiency. With over 600 machines currently operational, it is our goal to receive maximum precision in the products we manufacture.
Finishing
With a strong and compliant finishing process in place, we aim to achieve a zero defect goal at all our facilities. With skilled labor and experienced supervisors in place, each and every garment stitched at our units passed through multiple levels of scrutiny before being sent to the packing department.
Packing
Garment packing is done with absolute care and meticulousness. In-house stuffing is also carried out with great care. We follow the highest standards in packing that starts from carton allocation to dispatch.